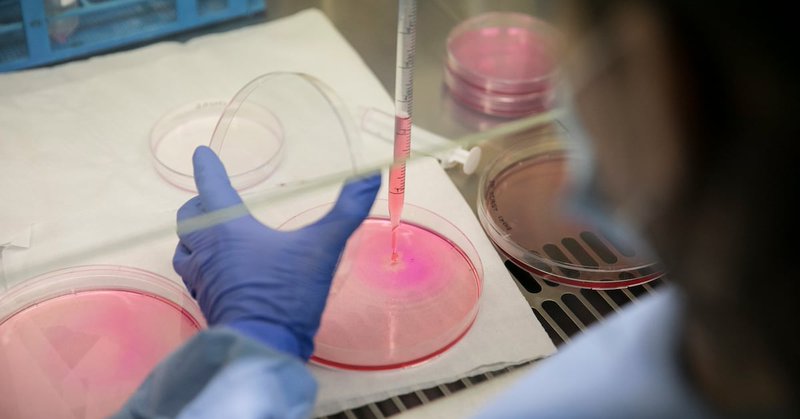
Tweet card summary image

Pere Ventayol
@windayol
Followers
440
Following
340
Media
16
Statuses
380
A veces podemos pasarnos años sin vivir en absoluto, y de pronto toda nuestra vida se concentra en un solo instante. Oscar Fingal O'Flahertie Wills Wilde
Joined May 2011
Biden amenaza con intervenir las patentes de los medicamentos con precios muy altos https://t.co/AlG0GmJkCn via @el_pais
elpais.com
La Administración avisa de que podría confiscarlas y entregarlas a otro fabricante si se han desarrollado con fondos públicos
1
3
7
🖋️ Webinar #MachineLearning asociado a #telemedicina y predicción de PROMs 📅 Lunes 6 noviembre 🕔 De 17h a 18h 👉 https://t.co/q5UOtOWgVE 👨⚕️ @ssalva4: #ALGOPROMIA de @Navetahealth predice mediante algoritmos con un 87% de prob de éxito el cuestionario #PatientExperience #P3CQ
0
4
5
Editorial sensato del @NEJM sobre el uso de mascarilla por los profesionales de centros sanitarios. Difícil resumen (tema complejo) pero propone usar la mascarilla en la interacción con los pacientes en función de vulnerabilidad y prevalencia infección https://t.co/9Bn3YQZzBv
8
34
80
𝗩𝗜𝗜 𝗝𝗢𝗥𝗡𝗔𝗗𝗔 𝗔𝗡𝗨𝗔𝗟 #lazaretofh23 | 📍Menorca 📖 Conferencia Magistral: La prescripción farmacéutica como objetivo en el horizonte: situación actual a nivel mundial 🗣️ Brett Simmonds Modera @pepguiu Vicepresidente @FIP_HPS
1
3
6
Estamos preparados. Ganas, pasión e ilusión. Pero nos falta una cosa. Tú. ¿Te apuntas? @ceciliamfll @jordinicolas1 @MonikedeMiguel @jamr_cho2
1
18
64
👉Hoy inicio de paciente con hidradenitis supurativa ⛔️Impacto elevado en la calidad de vida de los pacientes 🏹El abordaje con @Navetahealth nos permite centrar el foco en los aspectos que más preocupan al paciente #valuebasedhealthcare #proms
1
3
10
Posición editorial en El País: Por 1ª vez leo en prensa nacional artículos que también cargan a los laboratorios con su responsabilidad en los precios y retrasos de financiación. 👏👏👏 https://t.co/VjryjyqjXO
elpais.com
La transparencia y el interés público deben prevalecer en la fijación del coste de los fármacos del Sistema Nacional de Salud
0
9
35
Seguimiento de paciente con #asma y #Dermatitisatopica mediante #proms ✅POEM, NRS Picor, DLQi, QoLiad en dermatitis atópica ✅ACT y miniAQLQ en asma ‼️Módulos @Navetahealth en marcha 😊🙌 Non stop @farupeib @windayol @joaquinserlo @Costaisa
1
6
14
#naveta #PROMS #telefarmacia #ArtificialIntelligence #chatbox #pacientes #PREMs #adherencia #efectossecundarios #farmaciahospitalaria Esto no ha hecho más que empezar...😊🚀 @farupeib @windayol @joaquinserlo @raquelrodrin @Xisfecor @antonia_maestre @AnaGomezLobon
2
10
23
Seguro que, independientemente de los premios, este es el mejor regalo para los científicos gracias a los cuales nosotros hemos tenido la oportunidad de elegir nuestro lado de la foto. Ábrela👇🏼
0
29
60
@sefh_ @66CongresoSEFH @farma_gregorio @farmachuvi @noemartinezlop @LillyES @manolosesmero @xaviolba @Olguitxi @ceciliamfll @jamr_cho2 ¿ que es NAVETA? NAVETA es y será muchas cosas...pero entre ellas: #telemedicina #proms #calidaddevida #ehealth #resultadosensalud #InteligenciaArtificial #chatbox Es sobre todo dar VOZ a los pacientes, hacerles participes de su proceso asistencial, conciliando su vida.
2
6
17
📢🆕‼️Comité Asesor de Pacientes de la SEFH En el @66CongresoSEFH nuestra Presidenta @Olguitxi acaba de anunciar su puesta en marcha y nos presenta a sus miembros y actividades 👇👏👏 Un gran avance para mejorar resultados en salud, ser referentes y ganar visibilidad #sefh21
0
4
13
¿Qué ocurre cuando se juntan una bioingeniera y una farmacéutica friki? Que nos da por inventar perlas como "To BI or not to be"🤓 Descubre la aplicación de Business Intelligence mañana a las 9:15 en @66CongresoSEFH #sefh21 con Laura Llorente de @iClinicoMadrid y @farmaciaclinico
3
13
44
📚La fharmateca será un repositorio de 98 Documentos Formativos disponible en @sefh_ que permitirá una actualización de conocimientos para Farmacéuticos de Hospital, con aspectos teóricos, lecturas recomendadas y banco de preguntas, para preparación de #OPEs @jamr_cho2 #sefh21
2
27
108
"Study of breast cancer patients under trastuzumab treatment using big data" 💊💊💊 @Ruben_farma @lopez_briz @joseluis_pa @HospitalLaFe
#sefh21 @66CongresoSEFH
0
2
7
@bielmercadal1 @farupeib @windayol @joaquinserlo @AnaGomezLobon @Xisfecor @antonia_maestre No te lo pierdas
1
1
3
Mañana a las 9:15 #sefh21 en los mejores proyectos i+I , puesta de largo de nuestro @farupeib proyecto #NAVETA de gestión telemática de #ePROMS asociado a #telefarmacia
#patientmatters ✅Ya operativo en Baleares ✅Modulo Telefarmacia ✅Plataforma multipatologia-multiPROMS
1
7
16